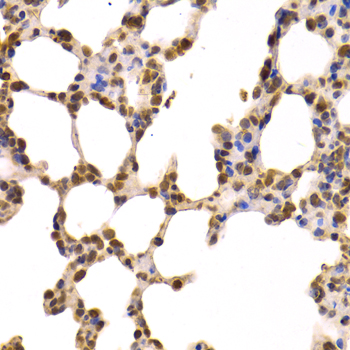

For quotations, please use our online quotation form, and you may also contact us by
service@kendallscientific.com
+1-888.733.6849 (Toll-free)
+1-617.299.7367 (Int’l))
+1-888.733.6849
Our customer service representatives are available 24 hours, Monday through Friday to assist you.| Reactivity | Human Mouse Rat |
| Tested applications | WB IHC IF IP RIP |
| Recommended Dilution | WB 1:500 - 1:2000 IHC 1:50 - 1:200 IF 1:20 - 1:100 IP 1:20 - 1:50 RIP 1:20 - 1:50 |
| Calculated MW | 58kDa |
| Observed MW | Refer to Figures |
| Immunogen | Recombinant Protein of human PKM |
| Storage Buffer | Store at -20℃. Avoid freeze / thaw cycles. Buffer: PBS with 0.02% sodium azide, 50% glycerol, pH7.3. |
| Concentration | j |
| Synonym | PKM2 ; TCB; PK3; PKM2 pyruvate kinase; muscle; CTHBP; PK2 |

Western blot analysis of extracts of various cells, using PKM antibody.
Immunohistochemistry of paraffin-embedded rat lung using PKM antibody at dilution of 1:100 (x400 lens).

Immunofluorescence analysis of HeLa cell using PKM antibody. Blue: DAPI for nuclear staining.

Immunofluorescence analysis of U2OS cell using PKM antibody. Blue: DAPI for nuclear staining.
Pyruvate kinase, a glycolytic enzyme, catalyses the conversion of phosphoenolpyruvate to pyruvate. In mammals, the M1 isoform (PKM1) is expressed in most adult tissues (1). The M2 isoform (PKM2), an alternatively-spliced variant of M1, is expressed during embryonic development (1). Studies found that cancer cells exclusively express PKM2 (1-3). PKM2 is shown to be essential for aerobic glycolysis in tumors (Warburg effect) (1). When the M2 isoform is switched to the M1 isoform, aerobic glycolysis is reduced and oxidative phosphorylation is increased in cancer cells (1). These cells also show decreased tumorigenicity in mouse xenografts (1). Recent studies show that the oncogenic forms of FGFR1 directly phosphorylate Tyr105 of PKM2 and thereby inhibit the formation of active tetrameric PKM2 (4). A PKM2 mutant found in cancer cells, in which Tyr105 is replaced by phenylalanine, leads to reduced cell proliferation in hypoxia and tumor growth in xenografts in nude mice (4). These findings suggest that the phosphorylation at Tyr105 is a critical switch for the metabolism in cancer cells that promotes tumor growth (4).
N/A